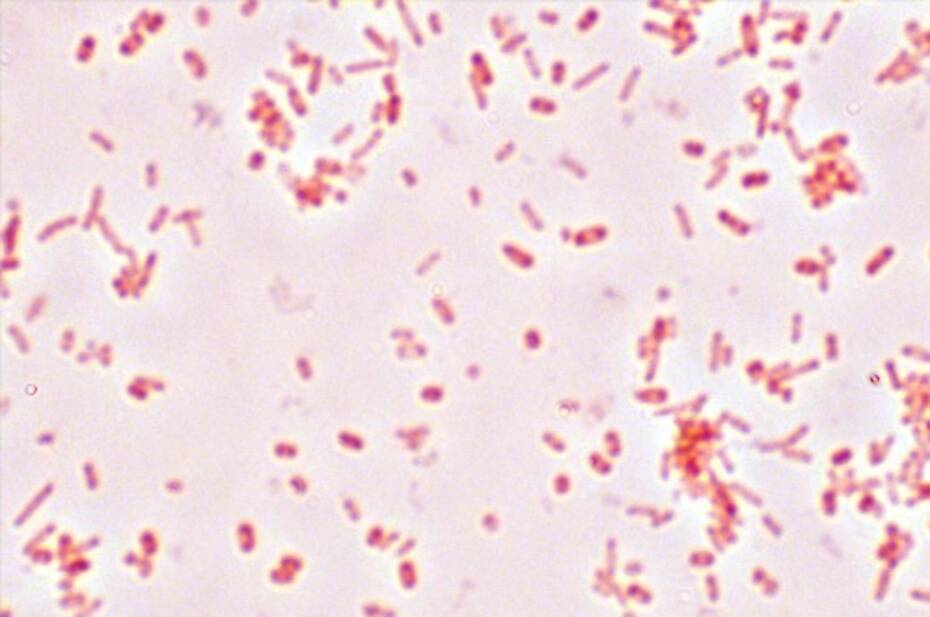
بكتيريا الأمعاء

- مُـحْـتَـوانَـا
- أسلوب حياة
- صحة
- بكتيريا الأمعاء
بكتيريا الأمعاء
يمتلئ جسم الأنسان بما لا يقل عن ألاف المليارات من البكتيريا، وهي ليست وحدها إذ تتشارك الجسم أيضًا مع الفطريات والفيروسات، ويحدد نوع البكتيريا وعددها الأم إذ تأتي معظم البكتيريا منها، والحمية الغذائية المتبعة، والعادات الحياتية. ويوجد في الأمعاء ما بين 300 -500 نوع من البكتيريا لكل منها ما يقارب 2 مليون وحدة جينية، وتغطي هذه البكتيريا كامل الجهاز الهضمي من الداخل، ويكون معظمها في الأمعاء الدقيقة والقولون، وتساعد هذه البكتيريا على معالجة الطعام، وتؤثر على جميع العمليات الحيوية من عملية الأيض إلى المزاج والجهاز المناعي، كما قد ترتبط بعدة أمراض مثل؛ داء السكري، والسمنة، وسرطان القولون، والاكتئاب.
بكتيريا الأمعاء والأمراض
تقترح الأبحاث العلمية والطبية أن بكتيريا الأمعاء عند الأشخاص الأصحاء تختلف عنها عند الأشخاص الذين يعانون من أمراض ما، وذلك إما بزيادة أو النقصان في أحد أنواعها أو قلة التنوع لمجموعات البكتيريا التي تتعايش معًا داخل الأمعاء، إذ تساعد بعض الأنواع على مقاومة الأمراض، ويساعد بعضها الأخر على التسبب بها، وفيما يلي بعض الترابط بين بكتيريا الأمعاء والأمراض المختلفة تبعًا للأطباء:
-السمنة وداء السكري وأمراض القلب: تؤثر بكتيريا الأمعاء على عملية الأيض، فهي تحدد كمية السعرات الحرارية التي يحصل عليها الجسم من الطعام، وكذلك كمية المواد الغذائية التي تمتصها الأمعاء، وإذا كان هنالك الكثير من البكتيريا في الأمعاء فإنها سوف تحول الألياف الغذائية إلى أحماض دهنية، مما يؤدي إلى تراكم الدهون في الكبد، وهو ما يؤدي بدوره إلى الإصابة بالسمنة وداء السكري وأمراض القلب.
-أمراض الأمعاء الالتهابية مثل داء كرون والتهاب القولون التقرحي: يعتقد بأن الأشخاص المصابين بهذه الأمراض يعانون من قلة أنواع البكتيريا المضادة للالتهابات في الأمعاء، وبالرغم من أن الترابط بين الأمرين ما زال غير مفهوم، إلا أنه يمكن القول بأن هنالك بعض أنواع البكتيريا التي تحث الجسم على مهاجمة الأمعاء.
-سرطان القولون: تظهر الأبحاث بان المصابين بهذا النوع من السرطان لديهم اختلاف في الكائنات الحية الدقيقة عن الأشخاص الأصحاء، وذلك بوجود مستويات أعلى من البكتيريا المسببة للأمراض.
-القلق والاكتئاب والتوحد: توجد الكثير من النهايات العصبية في الأمعاء والتي تربطها مباشرةً مع الدماغ، وهو ما يعرف بين الأطباء باسم "محور الأمعاء والدماغ"، وقد أظهرت الأبحاث ترابطًا بين بكتيريا الأمعاء وأمراض الجهاز العصبي المركزي مثل؛ القلق، والاكتئاب، والتوحد.
-التهاب المفاصل: يعتقد بأن المصابين بالتهاب المفاصل الروماتويدي يعانون من وجود بكتيريا معوية التهابية أكثر من عند الأشخاص الأصحاء.
طرق تحسين بكتيريا الأمعاء
تساهم البكتيريا المعوية في صحة الشخص، إذ تنظم عدة مهام وظيفية في الجسم، وقد تسبب نفس البكتيريا بعض الأمراض، وفيما يلي بعض الطرق التي يمكنها أن تساعد على تحسين صحة بكتيريا الأمعاء وصحة الجسم ككل:
-تنوع النظام الغذائي: يوجد مئات الأنواع من البكتيريا في الجسم وكل منها يحتاج لمواد غذائية معينة للبقاء على قيد الحياة، ويعد التنوع في البكتيريا الحية في الأمعاء أمرًا مهمًا لصحة الجسم.
-تناول الكثير من الخضروات والبقوليات والفواكه: تعد الخضروات والفواكه أكثر الأطعمة المغذية لبكتيريا الأمعاء، إذ تحتوي هذه الأطعمة على الألياف الغذائية التي لا يستطيع الجسم هضمها بل تستطيع البكتيريا ذلك مما يساهم في نموها وتطورها.
-الرضاعة بما لا يقل عن ستة أشهر: تتطور بعض البكتيريا في أمعاء الطفل قبل الولادة، وتتطور أكثر في أول سنتين من حياته، ويساعد حليب الأم المرضعة على تطور البكتيريا بشكل أفضل.
-تناول المعينات الحيوية: وهي مواد أو بكتيريا تساعد على نمو بكتيريا الأمعاء، وتوجد هذه المواد في كل من الخضروات والفواكه والزبادي.




















